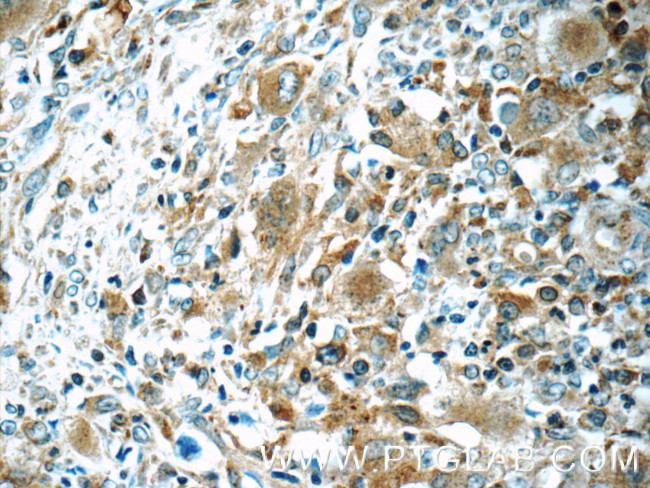
WASP Antibody in Immunohistochemistry (Paraffin) (IHC (P))

Search
Proteintech
WASP Polyclonal Antibody
{{$productOrderCtrl.translations['antibody.pdp.commerceCard.promotion.promotions']}}
{{$productOrderCtrl.translations['antibody.pdp.commerceCard.promotion.viewpromo']}}
{{$productOrderCtrl.translations['antibody.pdp.commerceCard.promotion.promocode']}}: {{promo.promoCode}} {{promo.promoTitle}} {{promo.promoDescription}}. {{$productOrderCtrl.translations['antibody.pdp.commerceCard.promotion.learnmore']}}
产品信息
10987-1-AP
种属反应
已发表种属
宿主/亚型
分类
类型
抗原
偶联物
形式
浓度
规格
纯化类型
保存液
内含物
保存条件
运输条件
产品详细信息
Immunogen sequence: MSGGPMGGR PGGRGAPAVQ QNIPSTLLQD HENQRLFEML GRKCLTLATA VVQLYLALPP GAEHWTKEHC GAVCFVKDNP QKSYFIRLYG LQAGRLLWEQ ELYSQLVYST PTPFFHTFAG DDCQAGLNFA DEDEAQAFRA LVQEKIQKRN QRQSGDRRQL PPPPTPANEE RRGGLPPLPL HPGGDQGGPP VGPLSLGLAT VDIQNPDITS SRYRGLPAPG PSPADKKRSG KKKISKADIG APSGFKHVSH VGWDPQNGFD VNNLDPDLRS LFSRAGISEA QLTDAETSKL IYDFIEDQGG LEAVRQEMRR QEPLPPPPPP SRGGNQLPRP PIVGGNKGRS GPLPPVPLGI APPPPTPRGP PPPGRGGPPP PPPPATGRSG PLPPPPPGAG GPPMPPPPPP P (1-400 aa encoded by BC012738)
靶标信息
The Wiskott-Aldrich syndrome family of proteins share similar domain structure, and are involved in transduction of signals from receptors on the cell surface to the actin cytoskeleton. The presence of a number of different motifs suggests that they are regulated by a number of different stimuli, and interact with multiple proteins. Recent studies have demonstrated that these proteins, directly or indirectly, associate with the small GTPase, Cdc42, known to regulate formation of actin filaments, and the cytoskeletal organizing complex, Arp2/3. Wiskott-Aldrich syndrome is a rare, inherited, X-linked, recessive disease characterized by immune dysregulation and microthrombocytopenia, and is caused by mutations in the WAS gene. The WAS gene product is a cytoplasmic protein, expressed exclusively in hematopoietic cells, which show signalling and cytoskeletal abnormalities in WAS patients. A transcript variant arising as a result of alternative promoter usage, and containing a different 5' UTR sequence, has been described, however, its full-length nature is not known.
仅用于科研。不用于诊断过程。未经明确授权不得转售。
生物信息学
蛋白别名: Actin nucleation-promoting factor WAS; eczema-thrombocytopenia; thrombocytopenia 1 (X-linked); WAS; WASp; Wiskott-Aldrich syndrome homolog; Wiskott-Aldrich syndrome protein; Wiskott-Aldrich syndrome protein homolog
基因别名: IMD2; SCNX; THC; THC1; U42471; WAS; WASP; WASPA
UniProt ID: (Human) P42768, (Mouse) P70315
Entrez Gene ID: (Human) 7454, (Rat) 317371, (Mouse) 22376